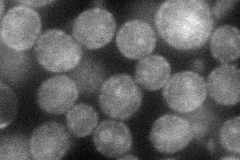
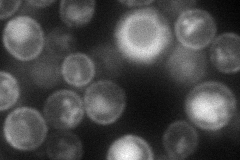
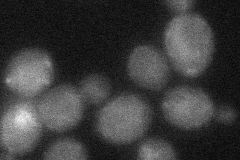

View description
Probable Mg(2+) transporter; overexpression confers increased tolerance to Al(3+) and Ga(3+) ions; plays a role in regulating Ty1 transposition
Localization:
Intensity:
Fold change:
Significance:
-
C’ GFP library in SD

below threshold14.99 -
N' NOP1pr-GFP in SD
cell periphery,punctate54.6603 -
N' TEF2pr-mCherry in SD
cell periphery,vacuole71.3275 -
N' NATIVEpr-GFP in SD

below threshold19.1431 -
N' TEF2pr-VC and Cyto-VN in SD
below threshold28.8467 -
C’ GFP library in SD+DTT

cytosol14.30.95No -
C’ GFP library in SD+H2O2

cytosol16.111.07No -
C’ GFP library in Starvation Media

cytosol16.531.1No -
C’ GFP library on the background of Pup2-DaMP

below threshold -
C’ GFP library on the background of CCT mutant

below threshold15.36371.0244No
